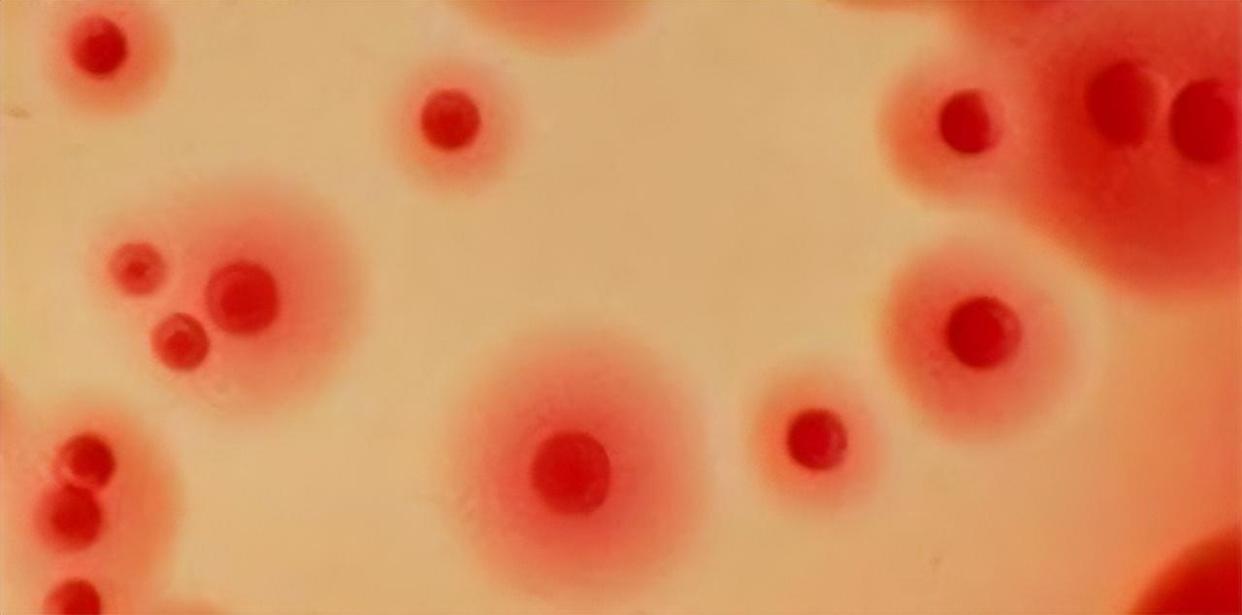
梅毒潜伏性,梅毒能在身体里潜伏几年没有症状

一提到梅毒,想必大家都听说过,梅毒是由梅毒螺旋体引起的慢性传染病, 通过性传播为主要途径占95%,少数人会通过接吻,血液接触,母婴喂养或者是接触受污染的衣物或器具而感染梅毒。
报告病历数显示,梅毒在我国甲乙类传染病报告中居第三位,且暂时没有下降的趋势。隐性比例近8成,患者延迟诊断明显。

由于我国特殊的社会文化,对梅毒患者存在着明显的偏见和恐惧感,梅毒患者通常有强烈的羞愧感、耻辱感,很容易延误诊断。
01
梅毒的诱因
1.不洁*生活性**
不洁*生活性**是感染梅毒的主要原因。梅毒几乎都是由*生活性**接触引起的。梅毒患者是传染源,传播性强、感染率高,通常在感染后7-60天发病。
2.自身免疫力低下
主要是指非性接解传染。主要是接触梅毒患者的分泌物或被污染的用具,如沾有分泌物的毛巾、脚布脚盆、衣被,甚至于厕所的马桶圈等,均可传染。
3.外伤感染
梅毒病菌可经皮肤或黏膜上的小小破裂伤口侵入体内,经过潜伏数日,病菌繁殖到足够的数目便开始发病。因此,要谨慎对待破裂的伤口。
4.通过母体传播
患有梅毒的孕妇可通过胎盘传染给胎儿,引起胎儿宫内感染,多发生在妊娠4个月以后,导致流产、早产、死胎或分娩胎传梅毒儿。
5.长期吸烟
根据调查表明,吸烟也是导致这种疾病的重要因素之一,吸烟能使人的抵抗力下降,发病率也会比不吸烟的患者多出几倍,并且发病率也跟吸烟的多少和烟龄有着密切的关系,吸烟也会促进梅毒的复发率。
02
梅毒喜欢玩“潜伏”,身体若出现5个变化,建议去医院做检查
1.梅毒疹
感染梅毒后,身上一般会出现疹子,但这些疹子一般不痛不痒,感染梅毒后,螺旋体进入血液中,会传播到皮肤黏膜以及内脏器官中,会导致全身的皮肤黏膜出现损伤或者病变。
梅毒疹的形态有很多种,比如像斑疹性的梅毒疹或者丘疹性的梅毒疹等等,梅毒患者的皮疹一般比较单一,以一种类型为主,经过治疗以后,疹子会很快的消退。

2.淋巴结肿大
此症状在梅毒早期也十分常见,淋巴结肿大通常出现在硬下疳后1-2周,以腹股沟或近卫淋巴结肿大最为常见。
肿大的淋巴结大小不一,质地较硬且不粘连、不破溃,也没有疼痛感。此症状通常可反复发作,若是有继发性感染,则肿大的淋巴结可能会出现隐痛感,部分患者按压淋巴结也会出现疼痛感。

3.硬下疳
硬下疳是一期梅毒的主要症状。主要表现为外阴部红斑、浸润、结节、破溃等,同时还会形成不痛不痒的溃疡,基底和周边区域是比较硬的。
部分患者还会伴有腹股沟淋巴结肿大的反应。不过这些症状通常都是非常轻微的,常常被患者忽视,从而耽误了病症的最佳治疗时机。

4.皮肤粘膜损害
当梅毒发展至三期时,就会出现皮肤粘膜损害的症状。此时患者局部皮肤上会出现结节性的梅毒疹和树胶肿。
同时体内神经系统、心血管系统及肝、脾、骨骼都有可能发生病变,严重的还会影响各脏器功能,这个时候不但有可能造成残疾,甚至会让患者丧失生命。
5.骨骼系统病变
发生于三期梅毒,常累及头、面部、骨和胫骨,患者主要出现关节畸形以及骨剧痛,疼痛感以夜间最明显。
另外二期梅毒扩散至全身,可出现发烧,咽喉肿痛,斑片状脱发,肌肉酸痛,视力下降等症状。三期梅毒累及心血管系统,可出现心悸、气短、心绞痛、心力衰竭等症状。

03
如何有效预防梅毒的出现?
1.养成良好卫生习惯
平时应该养成良好的卫生习惯,尽量不要到没有卫生保障的公共浴池洗澡,平时住酒店的时候,不要使用酒店的毛巾等生活用品。且应该禁止和他人共用内衣、*裤内**等私人物品,还应该勤洗内衣裤,这样可以有效的预防梅毒的发生。
2.不能使用公共澡堂
预防梅毒要做到不能使用公共澡堂,尤其在公共澡堂时,建议使用淋浴洗澡,同时淋浴之后也不要坐在公共澡堂的座椅上。而且在公共厕所时尽量使用蹲式马桶,这样才能很好的预防梅毒。

3.洁身自好
梅毒最主要的传播途径还是性接触。专家指出,只要坚守洁身自爱,不嫖娼,不卖淫,避免婚外*行为性**,只与一个*伴侣性**发生性关系,就能够基本上杜绝梅毒,这是预防梅毒等性病最基本,也是最有效的办法。
4.使用避孕套
据研究者统计,使用避孕套*交性**,可使梅毒的传染病几率下降70%以上,这是因为避孕套隔离了双方的生殖器皮肤粘膜,从而降低了梅毒的传染几率。提示大家,使用避孕套前必然要检查确认避孕套没有漏洞,排除气泡,这样才能确保有效预防梅毒。